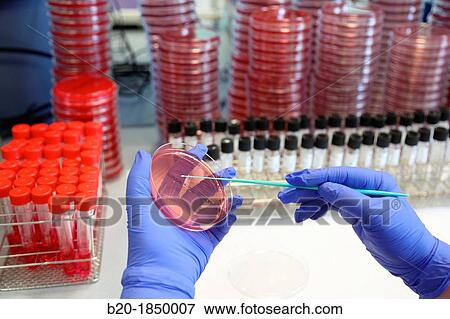

Fotosearch Royalty Free Stock Photography
Digital images licensed by Publitek, Inc.
Fotosearch and Photosearch are trademarks of Fotosearch, LLC
All rights reserved © 2025-10-24
Coproculture specimens, Microbiology Department, Donostia Hospital, San Sebastian, Donostia, Gipuzkoa, Basque Country, Spain Stock Photo
Coproculture specimens, Microbiology Department, Donostia Hospital, San Sebastian, Donostia, Gipuzkoa, Basque Country, Spain
b20-1850007 | age fotostock | Rights Managed
Add to Lightbox
Share Image
Keywords
adult, basque country, close-up, color image, coproculture, culture, department, depth of field, dof, donostia, equipment, focus on foreground, glove, guipuzcoa, hand, health, healthcare, horizontal, hospital, indoors, inside, interior, laboratory, laboratory equipment, low depth of field, medicine, microbiology, object, one, one person, people, petri dish, prepare, sample, san sebastian, science, selective focus, spain, specimen, technician, test, testing, thing, stock image, images, royalty free photo, stock photos, stock photograph, stock photographs, picture, pictures, graphic, graphics, fine art prints, print, poster, posters, mural, wall murals, b20-1850007, b20 1850007, b201850007
adult, basque country, close-up, color image, coproculture, culture, department, depth of field, dof, donostia, equipment, focus on foreground, glove, guipuzcoa, hand, health, healthcare, horizontal, hospital, indoors, inside, interior, laboratory, laboratory equipment, low depth of field, medicine, microbiology, object, one, one person, people, petri dish, prepare, sample, san sebastian, science, selective focus, spain, specimen, technician, test, testing, thing, stock image, images, royalty free photo, stock photos, stock photograph, stock photographs, picture, pictures, graphic, graphics, fine art prints, print, poster, posters, mural, wall murals, b20-1850007, b20 1850007, b201850007
Show Keywords













